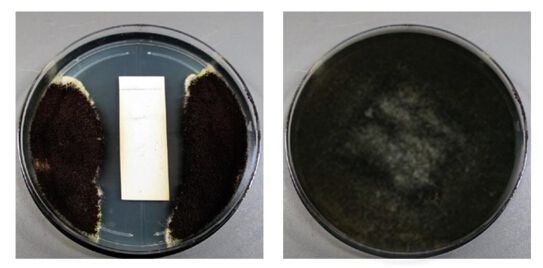

有趣的灵魂万里挑一 新风系统“心肺”部件对比评测
天凉好个秋。秋天在给人们带来丝丝凉意同时,与之而然的也带来了一些流行性疾病,秋季最容易感染呼吸道传染病,我们在说话、呼吸、打喷嚏、咳嗽时将病原体播散在空气中,被健康的人们通过口、鼻吸入体内而感染发病,其实最主要的原因之一就是在于空气不流通,进入秋天雾霾天气增多加上温度降低,使得室内窗户紧闭,空气无法有效流通,就会给流行性病毒可乘之机,所以强身健体的同时,给室内安装新风系统是目前解决通风换气难、室内空气质量差的最佳之选。
好看的皮囊千篇一律,有趣的灵魂万里挑一。 新风系统在外观设计上,各有千秋,无从有优劣对比。但每一个新风系统都有“灵魂”部件,那就是它的“心肺”器官——滤网+机芯,滤网和机芯好坏,直接关系到新风系统的使用寿命长短,能否有效过滤有害气体,能否避免二次污染和交叉感染,这都是决定这个新风系统价值的所在。
近日,小编有幸得到了森德新风系统的的专利部件——全热交换机芯(康舒膜),通过与市面上最常见的新风系统的纸膜做了一个对比,那究竟结果如何呢?请各位看官往下细细查阅。

新风系统的“肺”部件——滤网
新风系统适用于家庭、学校、幼儿园、商场、及高密集人流场所,24小时为室内实现通风换气,有效将室内污浊空气排出室外。可时间久了,滤芯变得污浊,就必须清洗更换,市面上多数的新风系统都是纸质膜,只能换不能洗,这无疑增加了用户的后期的使用成本。
同样作为空气净化系统的产品,新风机与家用空气净化器在净化原理上基本一致,主要依靠滤网来实现净化空气的效果,比如很多空气净化器会采用三层滤网设计,其能够对空气中的PM2.5、粉尘、花粉、异味、甲醛之类的污染物进行有效过滤,而在很多新风机上,同样也会采用类似的滤网搭配,其中就包括初效滤网、高效滤网、活性炭滤网,而三种滤网在作用上有着明显的区别。
其中初效滤网的作用比较单一,主要用来过滤空气中较大的颗粒物、灰尘、毛发等,可重复使用,在后期中不会产生额外的更换和维护费用;而高效滤网一般被称为HEPA滤网,它的主要材质为PP滤纸、玻璃纤维、复合PP PET滤纸所组成,能够高效过滤净化空气中的污染物,它对于空气中直径为0.3微米以下的微小颗粒物去除效率可达99%以上,而且不会产生有害气体的释放,是很多新风机必备的滤网,而缺点则是后期需要定期的进行更换滤网,后期会产生一定的使用费用,不过对于家用空气过滤而言,这类滤网也是更加健康且环保的选择。
最后一种是活性炭滤网,主要用来吸附空气中的各类有害物质,比如大家熟知的甲醛,同时它还具有良好的除异味的作用。当然,除了通过滤网来净化空气外,国外品牌的一些新风机会采用静电除尘净化空气的方式,两种方式在效果上可能差异不大,不同的则是静电除尘可以重复进行使用,而滤网则需要面对定期更换的问题,另外静电除尘不可避免的还会产生臭氧污染,因此消费者在选择时应该注意此类新风机对于臭氧的控制情况。

新风系统的“心脏”——全热回收机芯
而在新风系统中,热回收机芯无疑是最为核心的部件之一,很多客户看它的外形以为是过滤网,这是需要向用户解释清楚并且普及的。在新风系统中,热回收机芯与过滤网完全是两个部件。简单来说,过滤网是肺,热回收机芯才是心脏。它主要的功能就是能量回收,目前市面上的全热回收机芯的能量回收材料主要为纸质、金属铝箔和高分子的膜材料(森德康舒膜)。
铝箔材料只能够完成显热回收(温度回收),纸质和膜材料可以进行全热回收温度和湿度),纸质材料价格更加便宜,不过纸质滤芯有其无法回避的天然缺陷,比如纸质机芯在使用过程中容易沾满灰尘,而自身的材质又决定了纸芯不易清洁、不能沾水,同时在遇到潮湿的环境时,可能会容易滋生霉菌,而霉菌更会对空气质量造成相应的污染,造成空气的二次污染。
康舒膜抑菌效果对比
通常来说,选择新风机更有助于保持用户室内空气的流通,它通过24小时不间断的空气置换,可以使房间内新鲜空气的流通,而通过全热交换器进行换气的优势则是,在室内空气交换的同时,不会使室内空气的温度,受到室外空气温度的影响,从而始终保持室内舒适的温度环境,这也是森德康舒膜全热机芯的优势所在。

森德康舒膜到底比纸膜好在了哪?
目前市场上存在的热回收新风机机芯主要有三种材质:纸质、铝质、树脂。其中纸质机芯成本相对较低,但其在湿度较大的环境中容易变质、变形、滋生霉菌,不能清洗;铝质机芯相对更耐用,因为不容易实现湿度的交换,所以在热交转换率上效果并不理想,森德专利技术康舒膜则正好解决上面两类材质问题,康舒膜做为森德的独有技术,它采用一种加拿大进口的高分子合成薄膜,目前广泛应用森德康舒安新风系列产品,下面我们通过与纸膜对比,那么康舒膜到底有哪些优势呢?
显热与潜热回收效率高 ,避免交叉感染和串味
康舒膜所采用一种高分子聚合物,它的显热和潜热回收效率很高,其中全热回收效率达78%,湿度回收可达65%。逆流机芯比交叉流机芯效率更高,而气体及其它有害物质则不会渗透,避免了交叉感染和串味。

除显热交换外,康舒膜全热机芯能够让湿蒸汽透过,大大提高了热交换频率。比如:夏天新风中的湿度高于室内,湿蒸汽通过森德康舒膜渗透到回风侧,新风侧湿度降低,减少了室内的除湿负荷;冬天新风的湿度低于室内空气,回风侧的湿蒸汽通过森德康舒膜渗透到新风侧,增加了新风的湿度,减少了加湿负荷,提高新风的舒适度,也比显热交换芯更节能。
康舒膜可水洗、可防冻
森德康舒膜不仅克服了传统的纸机芯易长霉菌、不能清洗和寿命短的缺点,它最大的亮点则是可以直接用水冲洗,彻底清除了全热机芯的卫生死角,既健康卫生又经济实用。此外,森德康舒膜对结冻有一定的容忍度,机芯的防冻点远低于0℃,在变化的天气环境下,能保证稳定的全热交换效率。

某品牌纸膜水洗测试:
https://v.youku.com/v_show/id_XMzc2ODE4MzI3Ng==.html?spm=a2h3j.8428770.3416059.1
康舒膜水洗测试:
https://v.youku.com/v_show/id_XMzc2ODE4MzI2OA==.html?spm=a2h3j.8428770.3416059.1
https://v.youku.com/v_show/id_XMzc2ODE4MzI2NA==.html?spm=a2h3j.8428770.3416059.1
作为新风机中最为核心的部件,热交换器对于新风机至关重要,而通过比较康舒膜与纸膜对比测试,我们足以看出森德康舒膜在性能方面的最大的自身优势,可反复水洗,重复利用,大大节省用户的使用成本,在此基础上,更能防止交叉串味,保持室内的新鲜好空气的流通,真正做到了品效合一,能够使新风机系统成为真正“一劳永逸”的室内新风解决方案。
通过以上对市场上,新风系统核心部件的介绍和对比,相信很多人已经掌握了新风系统选购关键信息,在买新风系统时,纠结机芯好坏、使用成本、是否滋生霉菌这些问题的人们,现在知道该怎样选择了吗?
网址:有趣的灵魂万里挑一 新风系统“心肺”部件对比评测 https://www.jiaju82.com/news-view-id-631544.html
